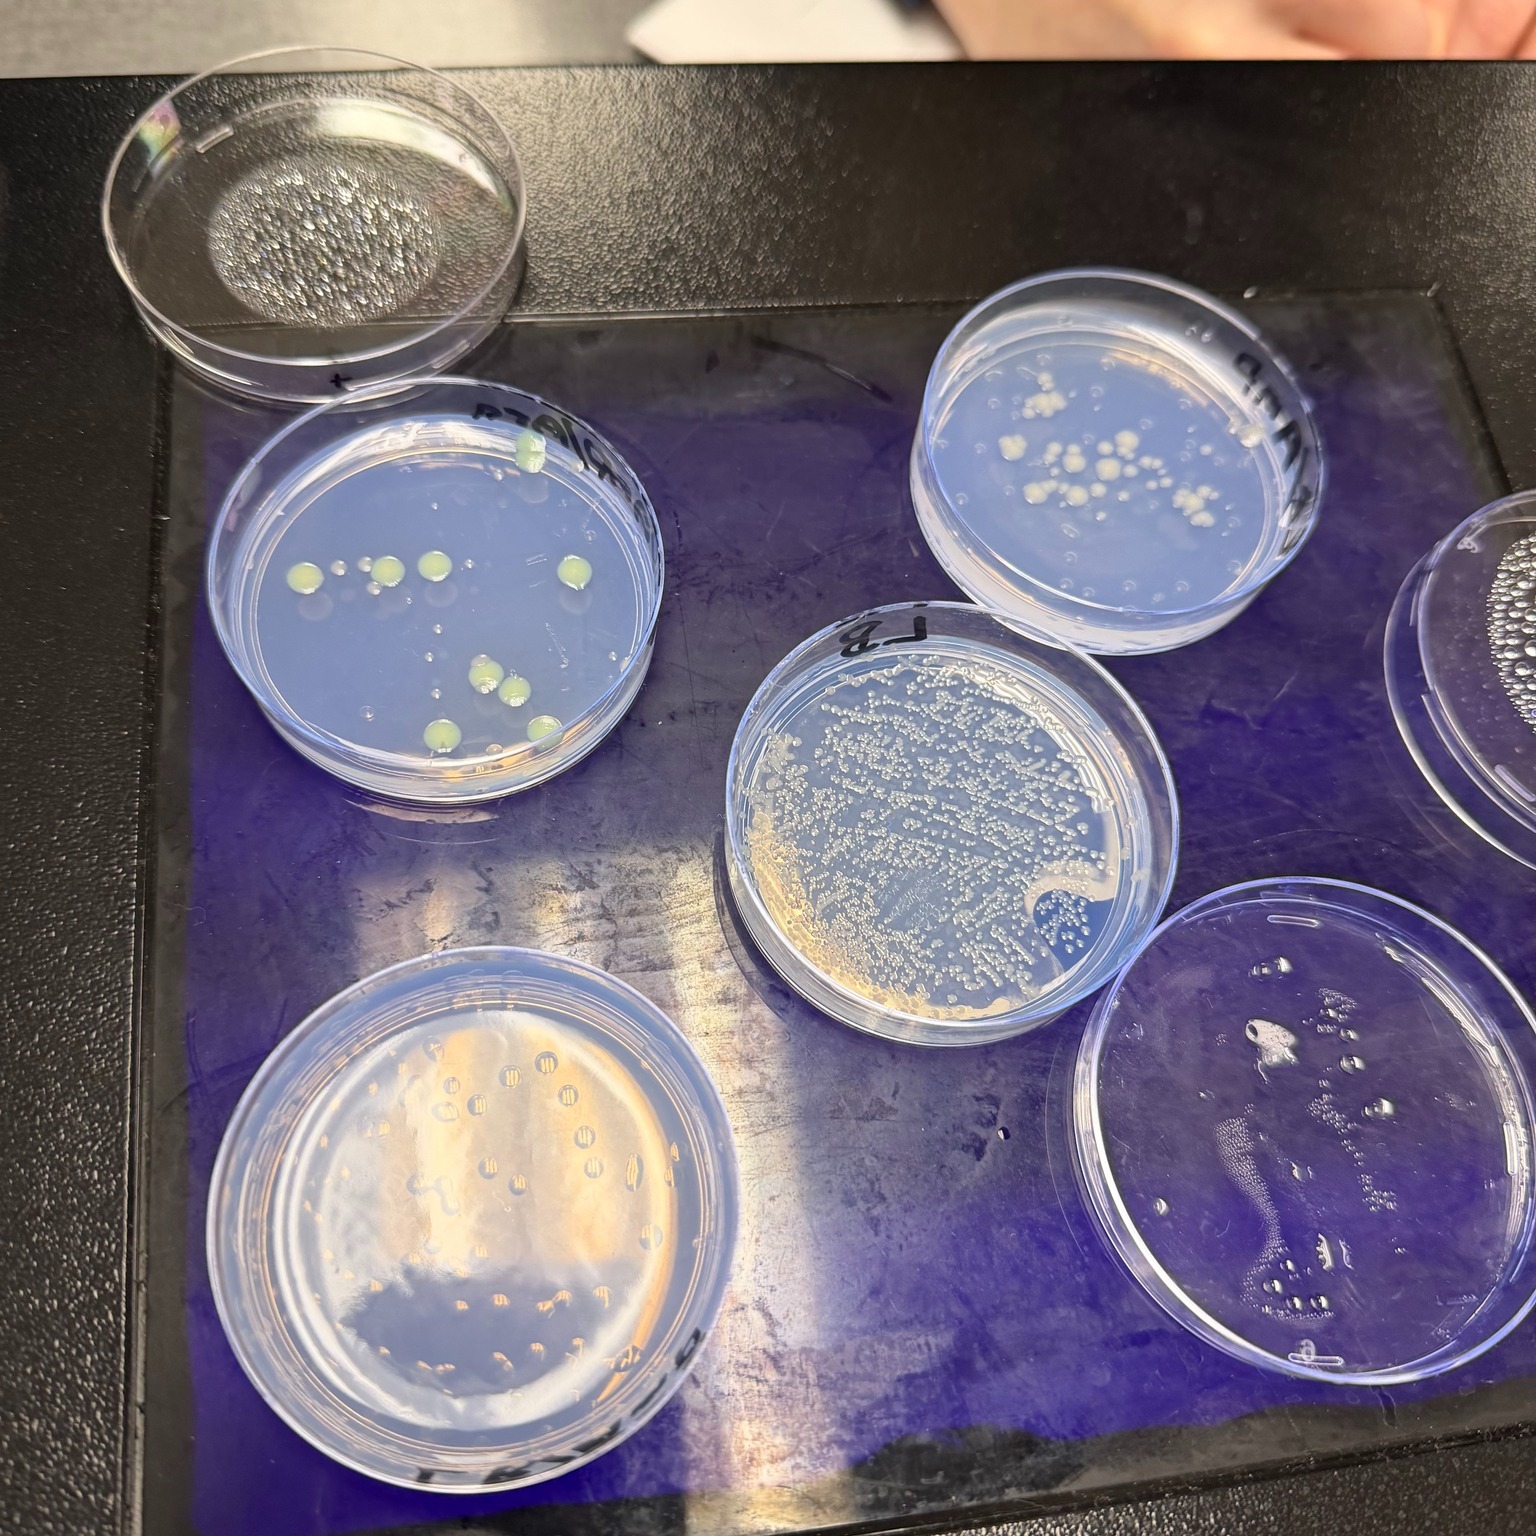

AP Biology students in Ms. Cassidy’s class conducted a bacterial transformation lab this week.
On Wednesday, students began transferring a gene for Green Fluorescent Protein (GFP), originally from a jellyfish, into bacteria to learn how genes move from one organism to another. When successful, the bacteria glow a brilliant green under ultraviolet light.
Today, students continued the lab and saw some of the finished samples already glowing green!